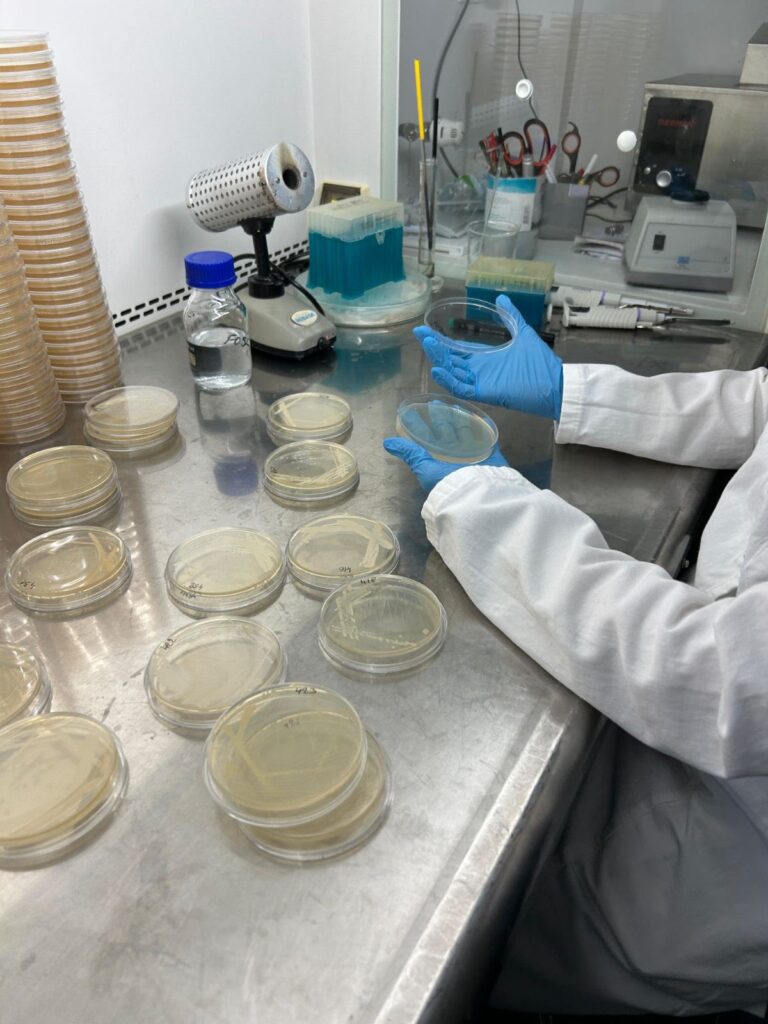

УПИС У ТОКУ ЗА 2026/2027. ГОДИНУ
ПРИЈАВА
Основне струковне студије
Специјалистичке струковне студије

Нутриционизам и дијететика – у поступку акредитације за 2026/2027. годину

Висока здравствено-санитарна школа струковних студија „Висан“ сваке године додељује стипендије најуспешнијим студентима:
Висока здравствено-санитарна школа струковних студија „Висан“ даје једногодишње стипендије најбољим студентима из претходне школске године, као и студенту прве године који је први на коначној ранг листи на свим студијским програмима.
Стипендисти за школску 2025/26 годину су:
3.11.2025. године
Висока здравствено-санитарна школа струковних студија „Висан“ у Београду наставља традицију подршке најбољим студентима. Поред додељних редовних стипендија које се сваке године обезбеђују за студенте са највишим просеком, у школској 2025/26. години Школа је доделила још 20 стипендија за новоуписане студенте из пет наставних база и то:
– 12 стипендија на основним струковним студијама (у трајању од 3 године), на студијским програмима:
– Струковни санитарно-еколошки инжењер – 4 студента
– Струковни нутрициониста-дијететичар – 2 студента
– Струковни фармацеут – 3 студента
– Струковна медицинска сестра – 3 студента
и
– 8 стипендија на специјалистичким струковним студијама (у трајању од 1 године), на студијским програмима:
– Специјалиста струковна медицинска сестра – 2 студента
– Специјалиста струковни физиотерапеут – 3 студента
– Специјалиста струковни медицински радиолог – 3 студента

Студенти који су завршили нашу Школу, са поносом, нас обавештавају да немају никакве проблеме приликом нострификације наше дипломе у иностранству и да се успешно запошљавају и настављају студије како у земљама широм Европе, тако и у Сједињеним Америчким Државама.
Пример ностирификације дипломе наше Школе у Норвешкоj погледајте овде
Пример нострификације дипломе наше Школе у Немачкој погледајте овде
Наша бивша студенткиња на студијском програму Струковна медицинска сестра, Весна Баћинац, нострификовала је успешно и без проблема диплому ВЗСШ „Висан“ у Сједињеним Aмeричким Државама (Флорида). Након тога је положила државни испит, добила лиценцу за рад и стекла статус Registerd Nurse са којим се и запослила на Флориди.
Весна Баћинац се захваљује нашој Школи на образовању које је стекла и на свеукопној сарадњи током и након школовања и позива све заинтересоване колеге да јој се јаве уколико желе да заснују радни однос или наставе школовање у Сједињеним Америчким Државама како би им помогла око нострификације дипломе, полагања државног испита, запослења или наставка школовања.
Без проблема до нострификације дипломе стечене на ВЗСШ „Висан“
Наша бивша студенткиња на студијском програму Струковна медицинска сестра, Хелена Галац, која данас ради у Саудијској Арабији, а претходно је радила у Италији, пренела нам је своја позитивна искуства у поступку признавања дипломе ВЗСШ „Висан“. Том приликом захвалила се на образовању које је стекла и које јој је омогућило да професионално напредује и оствари своје радно искуство у иностранству.
Изражавајући посебно захвалност наставницима, директору и управљачком кадру школе за посвећеност студентима, квалитетном образовању и подршци, коју је током студирања добијала, а која је имала значајан утицај на њен професионални развој и каријеру.
У свом допису Хелена се обраћа свим студентима наше школе који желе да заснују радни однос или наставе школовање у иностранству и нуди своју помоћ и подршку уколико им је потребна.
Награђени студенти Високе здравствено-санитарне школе “Висан” су ове године били Кристина Ђурић и Анђела Букумирић, студенкиње 2. и 3. године на студијском програму Струковна медицинска сестра.
Савез удружења здравствених радника Србије – Друштво медицинских сестара-техничара и бабица Србије је и ове године је додељивао “ПРИЗНАЊА – НАЈБОЉИMА” међу којима су награђене и наше студенткиње.
Признања су уручена 09.05. 2026. године на Свечаној академији у Пироту. На тај начин је уједно обележен и Међународни дан медицинских сестара, у спомен рођења Флоренс Најтигел.

На Свечаној Академији, одржаној у Врњачкој Бањи, поводом 12. маја – Међународног дана медицинских сестара, Висока здравствено-санитарна школа струковних студија “Висан” добила је од Удружења медицинских сестара – техничара и бабица Републике Србије још једно у низу признања за успешну дугогодишњу сарадњу и значајан допринос у развоју и афирмацији сестринске професије у Републици Србији.

ДРУШТВО САНИТАРНИХ ИНЖЕЊЕРА И ТЕХНИЧАРА СРБИЈЕ ПОД ПОКРОВИТЕЉСТВОМ МИНИСТАРСТВА ЗДРАВЉА СРБИЈЕ СТРУЧНА КОНФЕРЕНЦИЈА „ЗДРАВЉЕ ЈЕ НАШ ИЗБОР!“
(27.03. – 28.03.2026. године, Нови Бановци)
Висока здравственo-санитарна школа „Висан“ је ове године дала свој допринос раду стручне конференције „Здравље је наш избор!“ која је одржана од 27.03. до 28.03. године у организацији Друштва санитарних инжењера и техничара Србије под покровитељством Министарства здравља Србије.
Стручни скуп је окупио санитарно-еколошке инжењере техничаре из Србије, пруживши изузетну платформу за размену знања и унапређење њиховог рада. Фокус скупа је био на тесту „Знање о себи – ко сам ја?“ Учесници су разменили драгоцена искуства и примере добре праксе. Бројни бивши и садашњи студенти Високе здравствено-санитарне школе „Висан“ су дали свој допринос раду конференције. Догађај је успешно ојачао сарадњу између институција и још једном потврдио неопходност континуираног стручног усавршавања.



Студенти прве године Високе здравствено санитарне школе “Висан”, на студијском програму Струковни нутрициониста-дијететичар, на вежбама из предмета Микробиологија хране у наставној бази “Агроуник” са наставником Николом Ђорђевићем.
Како би употпунили и применили стечена теоретска знања из микробиологије хране, студенти су се и практично упознали са организацијом рада у микробиолошкој лабораторији. Студенти су на вежбама савладавали вештине као што су: узимање узорака и обрада материјала, припрема и употреба хранљивих подлога, примена метода стерилизације и дезинфекције, бактериолошке технике, микроскопирање и слично.

17.03.2026. године
Висока здравствено-санитарна школа струковних студија „Висан“ је била суорганизатор 13. ЈЕЕП Mеђународнe научнe агробизнис конференцијe – MAK 2026. „ЗЕЛЕНА ТРАНСФОРМАЦИЈА АГРОБИЗНИСА: ИНОВАЦИЈЕ КАО КЉУЧ ОДРЖИВЕ ПОЉОПРИВРЕДЕ” која се одржала на Копаонику, од 29. јануара до 1. фебруара 2026. године у Конгресном центру Гранд Хотела.
Конференција је била посвећена разним темама:
– Биотехнолошке и генетске иновације у пољопривреди
– Дигитална трансформација и паметна пољопривреда
– Еколошка одрживост и климатски изазови глобалне пољопривреде
– Економска и друштвена димензија одрживог агробизниса
– Здрава исхрана као фактор одрживог развоја и јавног здравља
– Зелена енергија и биоекономија у агробизнису
Осам наставника Високе здравствено-санитарне школе „Висан“ је представљало своје радове на овој конференцији, од којих су проф. др Марко Војводић, директор школе и проф. др Кристина Војводић били и у научном одбору.
4.2.2026. године
Наставник Високе здравствено-санитарне школе “Висан” проф. др Душан Вешовић дели своје знање и искуство као предавач на 7. конгресу здравствених радника у приватном сектору, у Crown Plazi у Београду, 19. и 20. фебруара 2026. године.
На 7. Међународном конгресу интегративне медицине у Порту, једном од најзначајнијих светских скупова у овој области, који је окупио више од 1.000 учесника из различитих земаља, проф. др Душан Вешовић одржао је предавање на тему холистичког приступа елиминацији осећаја сталног умора, заснованог на ФОРМУЛА ЗДРАВЉА протоколу.
Учешће на овом престижном међународном конгресу представља значајну међународну промоцију Високе здравствено-санитарне школе струковних студија “ВИСАН”, као образовне установе која активно прати и интегрише савремене европске и светске трендове у здравству, повезујући научна сазнања са клиничком праксом.
Кроз континуирано учешће својих наставника на међународним стручним и научним скуповима, ВИСАН омогућава студентима контакт са савременим и практично применљивим знањем, чиме се додатно потврђује њен положај као институције посвећене квалитетном образовању здравствених професионалаца.
Оваква међународна сарадња доприноси размени искустава са водећим европским и светским стручњацима, као и унапређењу наставних програма у складу са савременим стандардима здравствене струке.
На тај начин, Високе здравствено-санитарне школе струковних студија “ВИСАН” потврђује своју стратешку опредељеност ка интернационализацији образовања, подизању квалитета наставе и припреми студената за изазове савременог здравственог система.






Студенти специјалистичких студија санитарно-еколошког инжењерства са Високе здравствено-санитарне школе струковних студија “Висан” су 13.12.2025. године били у стручној посети фирми “Fun&Fit” у Београду. У оквиру предмета “Основи технологије чувања намирница” упознати су практично са овом темом.
Представљен им је производни погон са пак центром који послује у склопуDelta Holdinga. Проф. др Марија Стевановић и студенти су се уверили да ова компанија пратећи трендове на тржишту нутритивно добро избалансиране хране континуирано шири понуду производа, истовремено послујући по свим захтевима Међународног стандарда за храну ИФС (IFS – International Food Standard).


15.12.2025. године
Висока здравствено-санитарна школа „Висан“ је и ове године дала свој допринос раду Националног Конгреса главних медицинских сестара и бабица и професора здравственен неге са међународним учешћем, који је одржан од 26.11. до 30.11.2025. године на Тари у хотелу “Оморика”.
Конгрес je окупио здравствене раднике из Србије и иностранства, пруживши изузетну платформу за размену знања и унапређење сестринства и бабиштва. Фокус скупа био је на улози лидерства и комуникације у креирању иновација у образовању и постизању врхунског квалитета неге, уз посебан осврт на сестринске аспекте лечења Хочкиновог лимфома. Кроз бројне стручне радове и презентације из различитих медицинских области, од хирургије до педијатрије, учесници су разменили драгоцена искуства и примере добре праксе. Догађај је успешно ојачао сарадњу између институција и још једном потврдио неопходност континуираног стручног усавршавања.

За више информацијa погледајте Програм конгреса
2.12.2025.
Сарадња између Високе здравствено-санитарне школе „Висан“ и Клиничко-болничког центра „Звeздара“, започета још 2016. године, наставља да се развија на обострано задовољство. Као кључна наставна база, КБЦ „Звeздара“ већ деценију омогућава нашим студентима да кроз теоријску и практичну наставу стекну функционална знања из најважнијих стручних дисциплина.
Ова година донела је и формално признање за наш заједнички труд – Висока здравствено-санитарна школа „Висан“ је награђена Захвалницом за дугогодишњу сарадњу, чиме је још једном потврђен квалитет нашег партнерства.
Ова сарадња је одувек била двосмерна – док су наши студенти учили од најбољих, велики број запослених у КБЦ „Звeздара“ успешно је завршио основне и специјалистичке студије управо на нашим акредитованим програмима.
Посебно смо поносни на чињеницу да наша Школа сваке године, у складу са Уговором о пословној сарадњи, стипендира три студента из редова запослених у КБЦ „Звeздара“, подржавајући тако њихов професионални развој.
Верујемо да ћемо и у будућности наставити да заједнички образујемо будуће носиоце нашег здравственог система.

Наши студенти и студенти који су завршили студије ове године колективно су се нашли како би дали подршку за две академије. Прво на конгресу Академије техничко васпитачких струковних студија из Ниша, коју води председник студенског парламента као и председник СКАС-а Миланче Живковић, реализованом на Златибору од 2. до 4. новембра. А убрзо затим од 5. до 9. новембра на Artech конференцији чији су домаћини били Крагујевачки ректорат и Висока школа електротрхнике и рачунарства струковних студија Беград коју предводи председник студентског парламента и заменик председника СКАС-а Алекса Милојевић .
Наших 12 студената су присуствовали панелима и другим активностима, били на предавањима и дали свој допринос на оба конгреса. Конгрес је обележила конструктивна комуникација, нова познанства, као и активна размена искустава, мишљења и ставова студената. Једно лепо искуство и радни повратак на још једну позитивну активност.



10.11.2025. године
Национални конгрес здравствених радника Србије „Промените исход – заједно смо“ (са међународним учешћем), одржао се на Златибору у хотелу „Палисад“ у периоду од 29.10. до 02.11.2025. године. Проф. др Марко Војводић, директор школе је члан почасног одбора, а наставници и студенти Високе здравствено-санитарне школе „Висан“ су дали допринос раду конгреса.

На Конгресу су своја знања и искуства разменили стручњаци ургентне медицине, анестезиологије, стоматологе, фармације, биохемије, медицинске сестре и здравствени техничари свих профила, лабораторијски техничаре, санитарни техничари и инжењери, дијететичари-нутриционисти, физиотерапеути, радни терапеути, фармацеутски техничари, радиолошки техничари и други.
Организатор овог скупа билo je Савез удружења здравствених радника Србије под покровитељством Министарства здравља Републике Србије.
За више информацијa погледајте Програм конгреса
5.11.2025. годинe
Студенти Високе здравствено-санитарне школе „Висан“, на студијском програму Струковни нутрициониста дијететичар, са проф. др Маријом Стевановић, у оквиру предмета Прехрамбена технологија 1, посетили су 25.10.2025. године компанију „Данубиус“ из Новог Сада. Поред теорије, да би употпунили знање о преради житарица, практично су сагледали све фазе производње брашна и тестенине.
Било је више него корисно упознавање са фирмом која постоји више од 100 година, која је лидер у Србији у овој области и која има роботизовану производњу. Историја, квалитет и савремени трендови су нашим студентима послужили као инспирација за постављање питања и размишљања како ове, посебно нове производе уврстити у режим исхране. Највећи утисак, свакако, је оставио млин – који је на седам спратова, али потпуно аутоматизован, капацитета 300t дневно и којим управља један човек.



25.10.2025. године
Наставници и студенти Високе здравствено-санитарне школе „Висан“ дали су свој допринос учешћем на IV Међународном конгресу УЗПС са темом „ЕМПАТИЈА ЗДРАВСТВЕНИХ ПРОФЕСИОНАЛАЦА – ПУТ ДО РАЗУМЕВАЊА ДРУГИХ који је одржан на Тари у хотелу „Оморика“, у периоду од 16.10. до 19.10.2025. године.
Конгрес је својом свеобухватношћу пружио прилику да се на једном месту окупе колеге из Европе, региона и Србије. Преко 100 реномираних предавача и око 200 учесника међу којима су били и наставници и студенти Високе здравствено-санитарне школе „Висан“, из свих области медицине: интерна, хирургија, педијатрија, ортопедија и трауматологија, гинекологија и акушерство, психијатрија, инфектологија, урологија и нефрологија, анестезија ир еанимација, онкологија, примарн аздравствена заштита, здравственанега, интензивна нега, бабиштво, стоматологија, фармација, биохемија, епидемиологија,психологија као и професионалаца из сфере образовања учествовало је у раду конгреса.
Организатор овог скупа билo je Удружења здравствених професионалаца Србије УЗПС
За више информације погледајте Програм конгреса
24.10.2025. године
Група студената са Високе здравствено-санитарне школе струковних студија “Висан”, смер дијететичар нутрициониста, су 31.05.2025. у оквиру своје стручне праксе предмета Прехрамбена технологија 2, обишли Фарму Бела Река у срцу Хомољских планина (село Близнак, општина Жагубица).
Проф. др Марију Стевановић и заинтересоване студенте је кроз овај својеврсан пример еколошке фарме коза, оваца и јунади расе ангус, као и прераде млека водио Божидар Мишић, менаџер. 530 хектара земље, засади, стаје, млекара, дегустациони простор и кућа од индустријске конопље су учинили да се осећамо поносно што нешто овако постоји у нашој земљи.





У организацији Удружења медицинских сестара, техничара и бабица Републике Србије, а под покровитељством Министарства здравља Републике Србије и Коморе медицинских сестара и здравствених техничара Србије одржава се XXII Национални Симпозијум медицинских сестра, техничара и бабица са међународним учешћему у периоду од 14.05. до 18.05.2025. године у Хотелу “Бреза“ у Врњачкој Бањи. Професори и студенти Високе здравствено-санитарне школе „Висан“ учествују у раду Симпозијума који окупља стручњаке из области медицине, са циљем да размене искуства и представе иновативне приступе у лечењу и здравственој нези. Главне теме симпозијума су разноврсне и обухватају кључне области медицинске праксе, са посебним нагласком на мултидисциплинарни приступ и улогу медицинских сестара и бабица у савременом здравственом систему.
16.5.2025. године
Национални конгрес здравствених радника Србије „Живот пре свега“ (са међународним учешћем), одржаће се на Златибору у хотелу Палисад у периоду од 21.05. до 25.05.2025. године. Проф. др Марко Војводић, директор школе је члан почасног одбора, а значајан број наставника и студената Високе здравствено-санитарне школе „Висан“ узеће учешће у раду конгреса и искористити прилику да представе своје радове и уче од врхунских професионалаца како би постаали још бољи у спашавању живота.
На Конгресу где ће своја знања и искуства разменити стручњаци ургентне медицине, анестезиологије, стоматологе, фармације, биохемије,медицинске сестре и здравствени техничари свих профила, лабораторијски техничаре, санитарни техничари и инжењери, дијететичари-нутриционисти,физиотерапеути, радни терапеути, фармацеутски техничари, радиолошки техничари и други.

За више информацијa погледајте Програм конгреса
16.5.2025.
У оквиру међународне сарадње унутар Европске мреже високих школа за образовање медицинских сестара ENM, која укључује и размену студената, наша Школа је у периоду од 03.03. до 14.03. 2025. године била домаћин групи студената из иностранства који долазе на двонедељну практичну наставу у својству посматрача.
Студенти из иностранства су:
Julia Alberts (Швајцарска)
Sara Gavín Martínez (Шпанија)
Sara Gómez Barba (Шпанија)
Anna Stephani (Немачка)





Студенти прве године Високе здравствено санитарне школе “Висан”, на студијском програму Струковни нутрициониста-дијететичар, на вежбама из предмета Микробиологија хране у наставној бази “Агроуник” са наставником Николом Ђорђевићем.




19.03.2025. године
Висока здравствено-санитарна школа струковних студија „Висан“ даје једногодишње стипендије најбољим студентима из претходне године, као и студенту прве године који је први на коначној ранг листи на свим студијским програмима
Стипендисти за школску 2024/25 годину су:
(јун 2023. године)

У поновљеном процесу акредитације, Комисија за акредитацију и проверу квалитета Републике Србије решењем донетим од стране КАПК на 44. електронској седници одржаној 20.06.2023. године потврдила је да Висока здравствено – санитарна школа струковних студија „Висан“ испуњава све стандарде за акредитацију високошколске установе и студијског програма Струковни санитарно-еколошки инжењер.
Aкредитација високошколске установе
Струковни санитарно-еколошки инжењер
Ако размишљате и ако сте неодлучни шта уписати и којом се професијом бавити ми Вам нудимо савремене и атрактивне образовне профиле из области екологије и здравства на нивоу европског система образовања са могућношћу запослења или даљег усавршавања код нас и у иностранству.
Висока здравствено-санитарна школа “Висан” – школује студенте за занимања 21. века
Pro futuro – ЗА БУДУЋНОСТ!
Студијски програми су конципирани по угледу на програме водећих европских школа. У Високој здравствено-санитарној школи “Висан” посебна пажња се поклања индивидуалном развоју вештина где се кроз рад у малим групама и непосредан контакт са професорима негује слобода размишљања, креативност и подстиче лична иницијатива. Просторни и технички услови за студирање су такви да су опремљени савременим наставним средствима која омогућавају мултимедијалну презентацију.
Наставни облици (предавања, вежбе, семинари, колоквијуми, стручна пракса) и пропорција опште образовних, опште стручних и уже стручних дисциплина тако су подешени да омогућавају формирање квалитетних високо образовних стручњака, који могу непосредно по завршетку студија да се ангажују за успешно обављање свих врста послова за које су се школовали.
(04.04.2024. године)


Проф. др Марко Војводић, заменик директора Високе здравствено-санитарнe школе „Висан“ и помоћник директора за контролу квалитета, међународну сарадњу и маркетинг је, као и сваке године, присуствовао свечаној церемонији поводом Дана студената у организацији Студентске конференције академија струковних студија и високих школа Србије (СКАСС), у Народној скупштини Републике Србије.
Уз пуну подршку Министарства просвете, награђени су најбољи студенти струковних студија наше земље. Захваљујући уплатама студентских чланарина од стране академија и високих школа ове године су награђени најбољи студенти и пружена им је подршка за даљи каријерни развој. Овом приликом је студенту, Марку Несторовићу, уручена захвалница као најбљем студенту наше Школе.
4.4.2024. године
Студенти Високе здравствено-санитарне школе „Висан“, на студијском програму Струковни нутрициониста дијететичар, са проф. др Маријом Стевановић, посетили су 01.06.2024. године фабрику уља „Дунавка“ у Великом Градишту, где су обавили део стручне праксе.


01.06.2024. године
Представници студената Високе здравствено-санитарне школе „Висан“ учествовали су на Академијади 2024 и успели су да уђу у полуфинале у неколико спортова. Освојили су 3. место у стоном тенису.

19.5.2024. године
Студенти Високе здравствено-санитарне школе „Висан“, на студијском програму Струковни нутрициониста дијететичар, са проф. др Маријом Стевановић, посетили су 18.05.2024. године „Млекару Шабац“ и погоне прераде меса „Мачванка“ у Шапцу, где су обавили део стручне праксе.



18.05.2024. године
(15.05. до 19.05.2024. године)
Студенткиња Високе здравствено – санитарне школе „Висан“, једна од најталентованијих боркиња Србије – каратисткиња Емилија Антанасијевић, освојила је две златне медаље на Европском првенству у фудокан каратеу за омладинце одржаном од 15 до 19. маја у Термама Олимија у Словенији. Чланица карате клуба Црвена звезда у тешкој конкуренцији није устукнула пред изазовима и освојила је злато у категорији појединачна ката и у категорији тимска ката.
Емилија ће у јулу месецу као посебан гост учествовати на карате првенству у Америци, где ће покушати да оствари што боље резултате и нашој земљи донесе нова одличја.
За више информација погледајте видео из емисије са ТВ Прва.
Висока здравствено – санитарна школа „Висан“ је поносна што школује тако талентоване, вредне и посвећене студенте. Емилији честитамо на освојеним медаљама и желимо јој још пуно успеха у даљим такмичењима.

19.05.2024. године
Студенти наше школе учествовали су на Конгресу студената, који је одржан у студентском одмаралишту Ратко Митровић на Златибору, у периоду од 16. до 19. децембра 2024. године.
Током конгреса, на којем је учествовало 27 академија и виших школа из Србије, наши студенти су постигли запажене успехе у такмичењима: друго место у „Quiz Studenata“ , као и треће место на FIFA турниру за младе.
У оквиру конгреса, 17. децембра одржана је промоција наше школе, као и иницијатива „Отворена врата“, где су наши студенти одговарали на питања у вези са уписом и радом школе.
Овај конгрес је био одлична прилика за стицање нових знања, размену искустава и јачање сарадње међу студентима!



Наставници и студенти Високе здравствено-санитарне школе „Висан“ дали су свој допринос учешћем на Националном конгресу здравствених радника Србије „Изазови времена“ (са међународним учешћем), који је одржан на Златибору у хотелу Палисад, у периоду од 23.10. до 27.10.2024. године.
Организатор овог скупа биo je Савез удружења здравствених радника Србије, под покровитељством Министарства здравља Србије.
За више информације погледајте Програм конгреса






Висока здравствено-санитарна школа струковних студија „Висан“ даје једногодишње стипендије најбољим студентима из претходне године, као и студенту прве године који је први на коначној ранг листи на свим студијским програмима
Стипендисти за школску 2023/24 годину су:
(26.05.2024. године)
У недељу 26. маја 2024. године одржано је Првенство Србије у каратеу, аикибудоу и кобудоу.
Овом приликом су уручене Захвалнице за подршку Високој здравствено – санитарној школи стуковних студија “Висан” и директору Школе, Проф. др Марку Војводићу.



За више погледај овде.
26.05.2024. године
(22.05. до 26.05.2024. године)
Наставници и студенти Високе здравствено-санитарне школе „Висан“ дали су свој допринос учешћем на Националном конгресу здравствених радника Србије „Учимо из изазова“ (са међународним учешћем), који је одржан на Златибору у хотелу Палисад у периоду од 22.05. до 26.05.2024. године. Организатори овог скупа били су Савез удружења здравствених радника Србије, NNA– чланице ICN (Међународног већа медицинских сестара) и EFN (Европске федерације сестара) под покровитељством Министарства здравља Србије.

За више информације погледајте Програм Конгреса
26.05.2024. године
Професори и студенти Високе здравствено-санитарне школе „Висан“ учествовали су у раду VI Симпозијума у организацији Уније удружења медицинских сестара и здравствених техничара Републике Србије са главном темом “Утицај дигиталних технологија на здравље и квалитет живота“ одржаном од 15.05. до 19.05.2024. године на Златибору у Хотелу “Букет”.
За више информације погледајте Програм симпозијума
19.05.2024. godine
(07.05 – 17.05.2024. године)
Студенти Високе здравствено-санитарне школе „Висан“ дочекали су госте из Шпаније и Норвешке који су дошли на размену у оквиру Европске мреже високих школа за образовање медицинских сестара (European Network Module – ENM) од 07.05. до 17.05.2024. године.

У пролећном циклусу размене студенти Аne Ortiz Cantero и Lucía Dueñas Jiménez из Escuela Universitaria de Enfermería, Victoria – Gasteiz, Шпанија и Милица Гојковић и Stian Eng из Østfold University College, Норвешка похађали су двонедељну праксу у наставним базама Клиничко – болничког центра „Земун“, Клиничко – болничког центра „Звездара“ и Војномедицинској академији.


Своје утиске о посети наставним базама разменили су са представницима Високe здравствено-санитарне школе струковних студија “Висан”, директором – проф. др Марком Војводићем, помоћником директора за наставу и координатором за међународну сарадњу, Александром Маливук и примаријусом др мед. спец. Светланом Бановић, руководиоцем модула. Oвом приликом су добили сертификате о похађању двонедељне праксе.


17.05.2024. године
12. МАЈ 2024. ГОДИНЕ
Висока здравствено – санитарна школа „Висан“ добила је признање за дугогодишњу успешну сарадњу са УМСТБС и значајан допринос на развоју и афирмацији сестринске и бабичке професије у Републици Србији од Удружења медицинских сестара, техничара и бабица Републике Србије (УМСТБС) на свечаној академији поводом 12. маја Међународног дана медицинских сестара.

Представници Школе су поводом обележавања Дана сестринства присуствовали свечаним академијама у КБЦ Земун и на Војно – медицинској академији.
12.05.2024. године
Висока здравствено-санитарна школе „Висан“ учествовала је у раду конгреса који традиционално организује Удружење медицинских сестара, техничара и бабица Републике Србије.
Презентован је велики број стручних радова колега и студената. На конгресу су донесени многи закључци за унапређење сестринске професије. Изабрани су и награђени најбољи радови.
За више информације погледајте Програм конгреса
19.05.2024. године
Висока здравствено-санитарна школа „Висан“ је као дугогодишњи члан ЕNМ мреже учествовала на 32. Конференцији европске мреже високих школа зa школовање медицинских сестара.



На Конференцији се дискутовало о изазовима са којима се суочавају студенти, координатори и институције пре, током и након процеса размене студената и могућим решењима за превазилажење проблема и препрека која настају приликом размене студената. Учесници су међусобно поделили многобројна корисна искуства и договорили низ нових стратегија које ће се примењивати у даљем раду.
Једна од кључних тема била је и како заштити положај медицинске сестре и осигурати будућност сестринства. Поводом тога организована је међународна дебата на којој су учествовали бројни стручњаци из области медицине.
На Конференцији су учествовали проф. др Марко Војводић, директор Школе, и Александра Маливук, координатор за међународну сарадњу.


20.4.2024. године